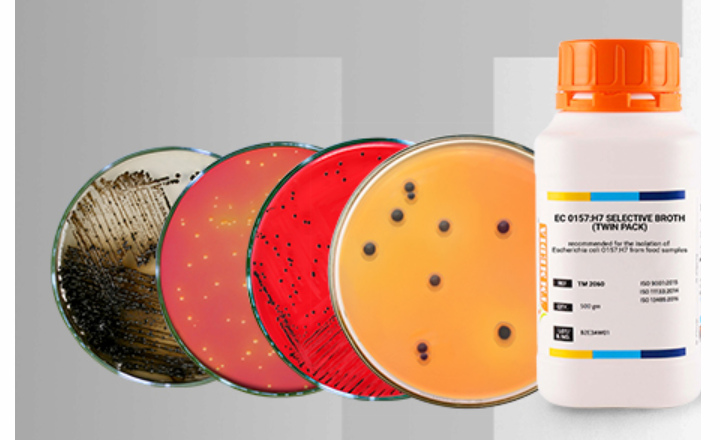
Precise Accurate Food Analysis Saves Lives

Why this matters:
- In Europe, Campylobacter is the leading cause of bacterial gastroenteritis and improper raw poultry handling is a major cause of transmission.1,2
- In the US, FoodNet reports approximately 20 diagnosed cases of Campylobacter infection per 100,000 population each year while the CDC estimates that the true burden is around 1.5 million illnesses annually.3
- This study by van der Vossen-Wijmenga et al.1 has real-world relevance that connects self-reported behaviours in the domestic setting with measurable infection risk via QMRA, focusing on illness cases and identifying mitigation strategies.
Key findings: van der Vossen-Wijmenga et al. have combined Dutch consumer survey data with laboratory testing to quantify hygiene behaviors influencing Campylobacter spread in the domestic environment1 Campylobacteriosis poses a significant public health burden in the European Union (EU), accounting for >137,000 confirmed cases per year, with the true burden likely higher due to underreporting.2
In the Netherlands, Campylobacter spp. accounts for the highest disease burden related to foodborne pathogens, causing an estimated 57,000 cases annually.4 Their study methods included a survey of 1,974 Dutch consumers about raw-chicken handling practices, quantitative microbial risk assessment (QMRA) modelling, and cross-contamination experiments measuring transfer rates from raw chicken to produce.
The survey revealed several raw poultry-handling behaviours among consumers:
- Safe behaviors: 95% of respondents thoroughly cook poultry
- Unsafe behaviours: 36% wash raw carcass before cooking and 77% do not replace dishcloths frequently enough.
- Females and households with children or pregnant members reported safer handling practices compared to males or households without.
- Scenario analysis highlighted thorough cooking as the most impactful intervention at home for reducing Campylobacter infection, followed by hand washing after handling raw chicken meat and replacing cutting boards.
- Quantitative experiments were conducted to measure the cross-contamination and transfer rate of Campylobacter jejuni from raw chicken fillet to cucumber: Replacing cutting boards reduced the transfer rate by 75% and knives by 57% compared to no replacement.
Implications: Public health messaging should emphasize avoiding carcass washing, highlight the importance of thorough handwashing and utensil replacement, and raise awareness of cross-contamination risks to reduce the incidence of campylobacteriosis.
References:
- van der Vossen-Wijmenga et al. 2025. Campylobacter in the domestic kitchen: Linking human and microbiological behaviour. International Journal of Food Microbiology. Vol. 441, page 111270.
- European Food Safety Authority (EFSA); European Centre for Disease Prevention and Control (ECDC). 2023. “The European Union One Health 2022 Zoonoses Report.” European Food Safety Authority Journal. Vol 21, Issue 12, e8442.
- CDC “About Campylobacter infection.” Accessed on October 1, 2025
- E. Benincà et al. 2024. The burden of disease of food-related pathogens in the Netherlands in 2022. RIVM Letter Report, pp. 1-41. Accessed on October 1, 2025